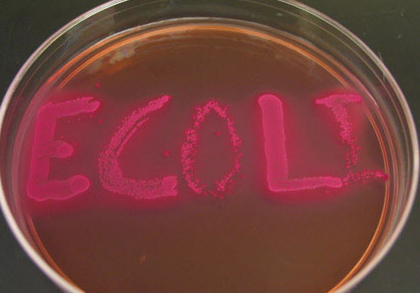

Τον ζεστό μήνα του Ιουλίου παρακολουθούμε σημαντικές εξελίξεις σε ένα τομέα μεγάλης ευαισθησίας τόσο για το εμπόριο όσο και για το καταναλωτικό κοινό.
Την Παρασκευή 1 Ιουλίου 2011, κατά τις 7 το βράδυ, μια ακόμα από τις γνωστές «φωτοβολίδες» με τις οποίες μας έχει συνηθίσει ο Ε.Φ.Ε.Τ. τους τελευταίους μήνες εξερράγη με μεγάλο θόρυβο:
Ο Ε.Φ.Ε.Τ., και συγκεκριμένα η Περιφερειακή Διεύθυνση Ανατολικής Μακεδονίας και Θράκης, κατά τη διάρκεια ελέγχου, διαπίστωσε τη διακίνηση α) κατεψυγμένου προϊόντος κιμά από βοδινό κρέας, β) κατεψυγμένα πικάντικα σουτζουκάκια από βοδινό κρέας, προέλευσης Γερμανίας, στα οποία ανιχνεύθηκε το παθογόνο βακτήριο Escherichia coli O157.
A. Πρόκειται για κατεψυγμένο προϊόν κιμά από βοδινό κρέας, σε κλειστή συσκευασία των 500 g (2 Χ 250 g), με την εμπορική επωνυμία «Marvest», που διακινήθηκε από τη γερμανική επιχείρηση «Griechenland Rind, Vion Hilden GmbH» (Westring 21, D-40721, Hilden) στην ελληνική εταιρεία «LIDL Hellas & ΣΙΑ Ο.Ε.». Το εν λόγω προϊόν έχει αριθμό παρτίδας L91185010 και ημερομηνία λήξης 6-11-2011.
Β. Πρόκειται για κατεψυγμένα πικάντικα σουτζουκάκια από βοδινό κρέας, σε κλειστή συσκευασία των 1000 g, με την εμπορική επωνυμία «Marvest», που διακινήθηκε από τη γερμανική επιχείρηση «Vion Convenience GmbH» (Postfach 1269 21, D-31502, Wunstorf) στην ελληνική εταιρεία «LIDL Hellas & ΣΙΑ Ο.Ε.». Το εν λόγω προϊόν έχει αριθμό παρτίδας L1 102 BT και ημερομηνία λήξης 8-11-2011.
Ο Ε.Φ.Ε.Τ. απαίτησε την άμεση ανάκληση / απόσυρση του συνόλου των παραπάνω προϊόντων από την ελληνική αγορά και ήδη βρίσκονται σε εξέλιξη οι σχετικοί έλεγχοι. Καλούνται οι καταναλωτές που έχουν ήδη προμηθευτεί τα ανωτέρω προϊόντα να μην τα καταναλώσουν.
Μαζί με την ανακοίνωση διανεμήθηκαν και φωτογραφίες των παραπάνω προϊόντων και όπως ήταν φυσικό, ξέσπασε σάλος. Στο βακτήριο Escherichia coli «αποδίδονται» μολύνσεις που μεταδίδονται στο ουροποιητικό και πεπτικό σύστημα και σε κάποιες περιπτώσεις, ακόμη και μηνιγγίτιδα ή πνευμονία καθώς και άλλες μολυσματικές ασθένειες. Η αλήθεια βέβαια είναι πολύ πιο «σύνθετη»: Το βακτήριο Escherichia coli χωρίζεται σε πολλές ομάδες και υποομάδες – τα περισσότερα είδη του βακτηρίου είναι αβλαβή – ακόμα και επωφελή για τον οργανισμό. Υπάρχουν όμως δύο συγκεκριμένοι τύποι του βακτηρίου (O157:H7 και O111:B4) που μπορούν να προκαλέσουν σοβαρές τροφικές δηλητηριάσεις στους ανθρώπους, ακόμη και θάνατο, ιδιαίτερα σε ηλικίες που έχουν αδύναμο ανοσοποιητικό σύστημα όπως οι ηλικιωμένοι και τα παιδιά.
Η ανακοίνωση του Ε.Φ.Ε.Τ. ήταν σαφής: …. ανιχνεύθηκε το παθογόνο βακτήριο Escherichia coli O157….. Παρ΄ όλα αυτά στο σχετικό Δελτίο Τύπου διατυπώνεται η «προτροπή» (Καλούνται οι καταναλωτές) να μην καταναλώσουν τα προϊόντα αυτά αλλά αποφεύγεται η (λογική) σύσταση επιστροφής των προϊόντων στα καταστήματα της αλυσίδας.

Την αμέσως επόμενη ημέρα (Σάββατο 2 Ιουλίου 2011) η Lidl Ελλάς σε σχετική ανακοίνωσή της αναφέρεται σε υποψία παρουσίας (και όχι δεδομένη ανίχνευση που αναφέρει ο Ε.Φ.Ε.Τ.):
Για δύο κατεψυγμένα προϊόντα βοδινού κιμά με την εμπορική επωνυμία «Marvest» του γερμανού προμηθευτή Vion υπάρχει η υποψία παρουσίας του βακτηρίου Escherichia coli. Η Lidl Hellas για προληπτικούς λόγους έχει ήδη αποσύρει άμεσα τα παραπάνω προϊόντα από τους χώρους πώλησης. Οι αρμόδιες αρχές στην Ελλάδα έχουν την υποψία παρουσίας του βακτηρίου Escherichia coli για τα προϊόντα με κιμά από βοδινό κρέας του προμηθευτή Vion. Η εταιρία παραγωγής είναι μία διεθνής εμπορική επιχείρηση διανομής προϊόντων κρέατος. Αναφορικά με την Lidl Hellas η παραπάνω ενημέρωση ενδεχομένως να αφορά στους παρακάτω κωδικούς:
«Κατεψυγμένος κιμάς από βοδινό κρέας σε κλειστή συσκευασία των 500 γρ. με την εμπορική επωνυμία «Marvest». Το εν λόγω προϊόν έχει ημερομηνία λήξεως 06.11.2011 (παρτίδα L 91185010) και οβάλ σφραγίδα έγκρισης της εγκατάστασης DE NW EV-304EG.»
«Κατεψυγμένα πικάντικα σουτζουκάκια από βοδινό κρέας με την εμπορική επωνυμία «Marvest» σε κλειστή συσκευασία των 1000 γρ. Το εν λόγω προϊόν έχει ημερομηνίαλ ήξεωςς 08.11.2011 (παρτίδα L 1102BT) και οβάλ σφραγίδα έγκρισης της εγκατάστασης DE EV-37 EG.»
Η Lidl Hellas κατόπιν ενημέρωσης των αρχών και για λόγους προληπτικής προστασίας των καταναλωτών αντέδρασε άμεσα αποσύροντας τα παραπάνω προϊόντα από τους χώρους πώλησης».
Και ενώ ο θόρυβος και ο γενικότερος προβληματισμός συνεχιζόταν με την ίδια ένταση, η Lidl Ελλάς στις 6 Ιουλίου 2011 έκανε μια καινούργια ανακοίνωση η οποία έχει ως εξής:
Μικροβιολογικές αναλύσεις ανεξάρτητων ελεγκτικών Ινστιτούτων διαπιστώνουν ότι τα προϊόντα κιμά της Lidl δεν αποτελούν κίνδυνο για την υγεία των καταναλωτών.
Πρόσφατα τέθηκε από τις ελληνικές Αρμόδιες Αρχές ζήτημα παρουσίας του μικροβίου (STEC/VTEC) E.coli O157:H7 στον κατεψυγμένο κιμά από βοδινό κρέας με ημερομηνία λήξεως 06.11.2011 και στα καταψυγμένα σουτζουκάκια με ημερομηνία λήξεως 08.11.2011, προϊόντα της Εταιρίας Vion, τα οποία διακινήθηκαν από τη Lidl Hellas.
Στη Lidl Hellas δεν υπάρχουν μέχρι αυτή τη στιγμή αποτελέσματα ελέγχων, τα οποία να επιβεβαιώνουν την παρουσία βεροτοξινογόνου βακτηρίου E.coli (STEC/VTEC) O157:H7.
H Lidl δεσμεύεται απέναντι στους καταναλωτές της και δίνει ιδιαίτερη έμφαση στην ασφάλεια και στην ποιότητα των τροφίμων της. Σας διαβεβαιώνουμε, ότι λαμβάνουμε όλα τα απαραίτητα μέτρα για την προστασία της υγείας των καταναλωτών.
Τα παραγόμενα κάτω από αυστηρά μέτρα υγιεινής τρόφιμα, ελέγχονται συνεχώς από διαπιστευμένα μικροβιολογικά εργαστηριακά Ινστιτούτα σε Γερμανία και Ελλάδα.
Με την αφορμή αυτή, η Lidl Hellas υπέβαλε σε επανέλεγχο τα παραπάνω αναφερόμενα τρόφιμα. Τα αποτελέσματα των αναλύσεων απέδειξαν ότι τα τρόφιμά μας είναι ασφαλή, αφού δεν ανιχνεύτηκε ο βεροτοξινογόνος ορότυπος E.coli (STEC/VTEC) Ο157:H7.
Αυτό επιβεβαιώνεται και μέσω της πραγματογνωμοσύνης του κ. Καθ. Δρ. Ιατρ. Στυλιανού Χατζηπαναγιώτου, Αναπληρωτή Καθηγητή Μικροβιολογίας της Ιατρικής Σχολής του Εθνικού και Καποδιστριακού Πανεπιστημίου Αθηνών, που υποβλήθηκε στην Lidl Hellas.
Η Lidl Hellas επισημαίνει ρητά ότι ακόμα και σε περίπτωση που είχε ανιχνευθεί το βεροτοξινογόνο βακτήριο E.coli (STEC/VTEC) O157:H7 στα προϊόντα κρέατος, τα βακτήρια θα είχαν εξουδετερωθεί στο μαγείρεμα από τη θερμότητα. Σε όλες τις συσκευασίες κρέατος της Lidl υπάρχει διακριτά η οδηγία για «καλό μαγείρεμα πριν την κατανάλωση!».

Με άλλα λόγια, από την μία πλευρά ο ΕΦΕΤ μας πανικοβάλλει λέγοντας πως ανιχνεύτηκε ο παθογόνος τύπος Ο157:H7 του βακτηρίου E. Coli σε δύο προϊόντα που διατίθενται από τα ράφια της Νο 2 αλυσίδας λιανικής της χώρας μας και από την άλλη πλευρά ένας Καθηγητής του Ε.Κ. Πανεπιστημίου μας διαβεβαιώνει πως η πραγματογνωμοσύνη που έκανε (προφανώς αμέσως μετά την ανακοίνωση του ΕΦΕΤ) δεν διαπίστωσε την ύπαρξη του παθογόνου τύπου του βακτηρίου στα (ίδια) προϊόντα που αποσύρθηκαν.